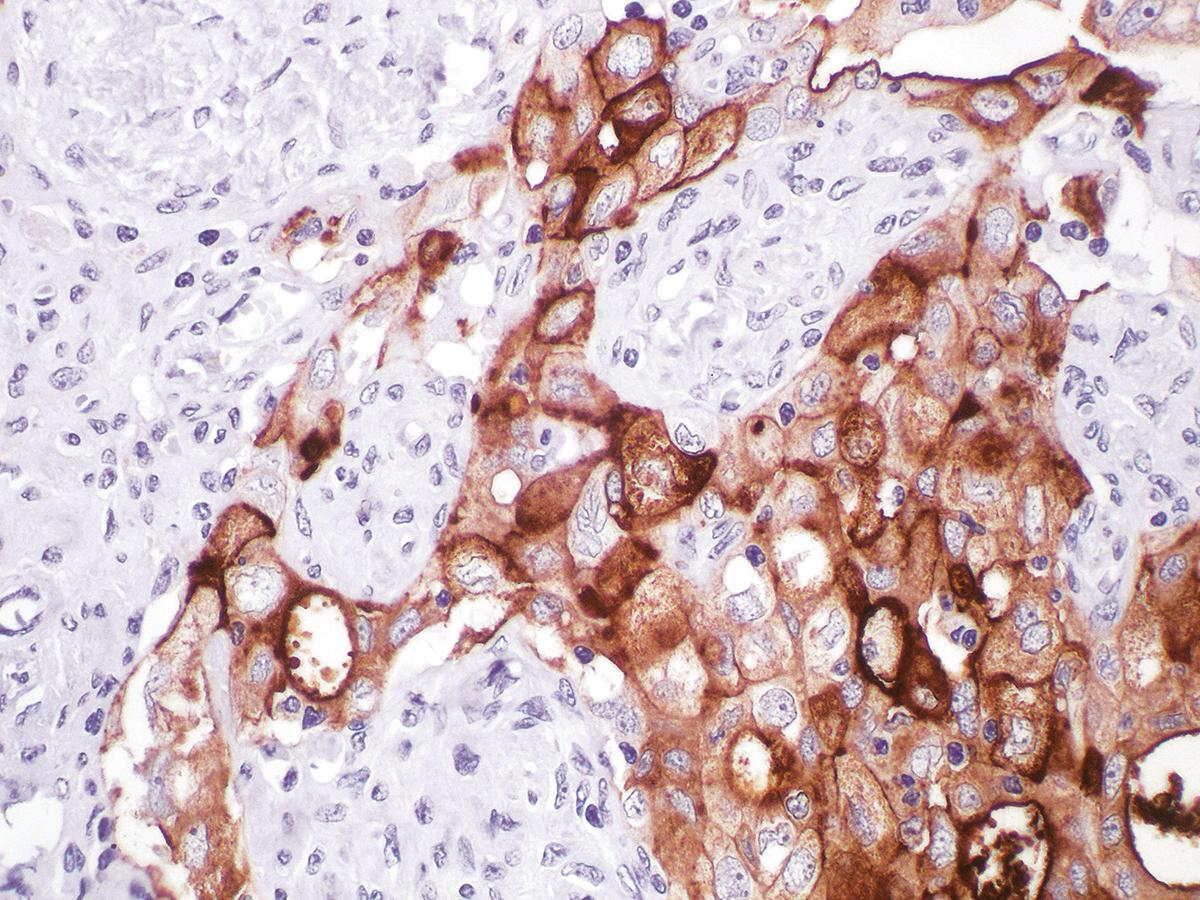

Anti-CA-125 Monoclonal Antibody (Clone:IHC125)
Shipping Info:
For estimated delivery dates, please contact us at [email protected]
| Format : | Purified |
| Amount : | 1 ml |
| Purification : | Protein A/G Chromatography |
| Storage condition : | Store at 2°C - 8°C. |
CA-125 is normally found in epithelial cells of Fallopian tube, endometrium and endocervix, pancreas, colon, gall bladder, stomach, kidney, apocrine sweat gland, mammary gland, and mesothelial cell lining of pleura, pericardium and the peritoneum. Staining with CA-125 reacts positively with ovarian malignancies, cervical carcinoma, endometrial and bladder adenocarcinoma, seminal vesicle carcinoma, and anaplastic lymphoma.
Recommended dilutions: Immunohistochemical analysis: 1:100 - 1:200. However, this need to be optimized based on the research applications.
For Research Use Only. Not for use in diagnostic/therapeutics procedures.
|
There are currently no product reviews
|

.png)











